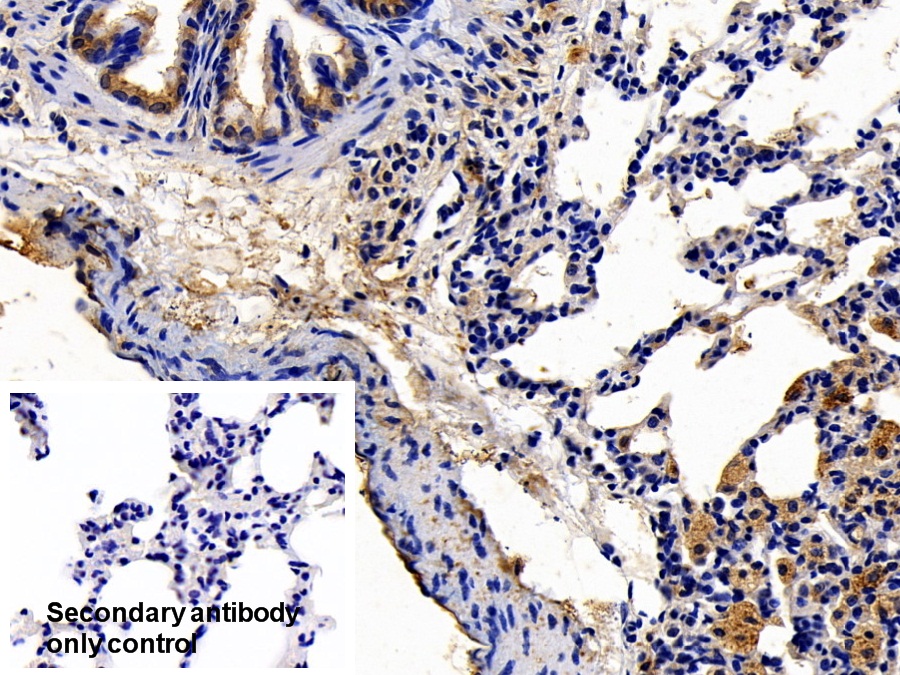

Polyclonal Antibody to Chemokine C-X3-C-Motif Ligand 1 (CX3CL1)
NTN; ABCD3; C3Xkine; CXC3; CXC3C; NTT; SCYD1; ABCD3; FKN; Neurotactin; Fractalkine; Small Inducible Cytokine Subfamily D(Cys-X3-Cys)Member 1
- Product No.PAA040Ra01
- Organism SpeciesRattus norvegicus (Rat) Same name, Different species.
- SourcePolyclonal antibody preparation
- HostRabbit
- Potencyn/a
- Ig Type IgG
- PurificationAntigen-specific affinity chromatography followed by Protein A affinity chromatography
- LabelNone
- Immunogen RPA040Ra01-Recombinant Chemokine C-X3-C-Motif Ligand 1 (CX3CL1)
- Buffer Formulation0.01M PBS, pH7.4, containing 0.05% Proclin-300, 50% glycerol.
- TraitsLiquid
- Concentration0.5mg/ml
- Organism Species MoreHomo sapiens (Human)
- ApplicationsWB; IHC
If the antibody is used in flow cytometry, please check FCM antibodies. - DownloadInstruction Manual
- UOM 20µl100µl 200µl 1ml 10ml
- FOB
US$ 103
US$ 239
US$ 342
US$ 855
US$ 3420
For more details, please contact local distributors!
SPECIFITY
The antibody is a rabbit polyclonal antibody raised against CX3CL1. It has been selected for its ability to recognize CX3CL1 in immunohistochemical staining and western blotting.
USAGE
Western blotting: 0.01-2µg/mL;
Immunohistochemistry: 5-20µg/mL;
Immunofluorescence:5-20µg/mL;
Optimal working dilutions must be determined by end user.
STORAGE
Store at 4°C for frequent use. Stored at -20°C in a manual defrost freezer for two year without detectable loss of activity. Avoid repeated freeze-thaw cycles.
STABILITY
The thermal stability is described by the loss rate. The loss rate was determined by accelerated thermal degradation test, that is, incubate the protein at 37°C for 48h, and no obvious degradation and precipitation were observed. The loss rate is less than 5% within the expiration date under appropriate storage condition.
GIVEAWAYS
INCREMENT SERVICES
-
 Antibody Labeling Customized Service
Antibody Labeling Customized Service
-
 Protein A/G Purification Column
Protein A/G Purification Column
-
 Staining Solution for Cells and Tissue
Staining Solution for Cells and Tissue
-
 Positive Control for Antibody
Positive Control for Antibody
-
 Tissue/Sections Customized Service
Tissue/Sections Customized Service
-
 Phosphorylated Antibody Customized Service
Phosphorylated Antibody Customized Service
-
 Western Blot (WB) Experiment Service
Western Blot (WB) Experiment Service
-
 Immunohistochemistry (IHC) Experiment Service
Immunohistochemistry (IHC) Experiment Service
-
 Immunocytochemistry (ICC) Experiment Service
Immunocytochemistry (ICC) Experiment Service
-
 Flow Cytometry (FCM) Experiment Service
Flow Cytometry (FCM) Experiment Service
-
 Immunoprecipitation (IP) Experiment Service
Immunoprecipitation (IP) Experiment Service
-
 Immunofluorescence (IF) Experiment Service
Immunofluorescence (IF) Experiment Service
-
 Buffer
Buffer
-
 DAB Chromogen Kit
DAB Chromogen Kit
-
 SABC Kit
SABC Kit
-
 Long-arm Biotin Labeling Kit
Long-arm Biotin Labeling Kit
-
 Real Time PCR Experimental Service
Real Time PCR Experimental Service
| Magazine | Citations |
| World Journal of Gastroenterology | Preliminary study correlating CX3CL1/CX3CR1 expression with gastric carcinoma and gastric carcinoma perineural invasion NCBI: PMC3989981 |
| International Journal of Colorectal Disease | Downregulation of CX3CR1 ameliorates experimental colitis: evidence for CX3CL1-CX3CR1-mediated immune cell recruitment. pubmed:27942903 |
| Frontiers in Cellular and Infection Microbiology | Reduced CX3CL1 Secretion Contributes to the Susceptibility of Oral Leukoplakia-Associated Fibroblasts to Candida albicans. pubmed:27891323 |
| Blood Coagul Fibrinolysis | Low shear stress upregulates the expression of fractalkine through the activation of mitogen-activated protein kinases in endothelial cells Pubmed:29406386 |
| Journal of Neuroinflammation | The prenatal challenge with lipopolysaccharide and polyinosinic: polycytidylic acid disrupts CX3CL1-CX3CR1 and CD200-CD200R signalling in the brains of … Pubmed: 32829711 |
| Cells | Maternal Immune Activation Sensitizes Male Offspring Rats to Lipopolysaccharide-Induced Microglial Deficits Involving the Dysfunction of CD200–CD200R and … Pubmed: 32664639 |
| Journal of Neuroinflammation | CX3CR1-microglia mediates neuroinflammation and blood pressure regulation in the nucleus tractus solitarii of fructose-induced hypertensive rats Pubmed: 32532282 |
| JOURNAL OF PERIODONTAL RESEARCH | Potential biomarkers reflecting inflammation in patients with severe periodontitis: Fractalkine (CX3CL1) and its receptor (CX3CR1) 33641164 |